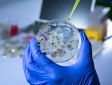

На 17 си го продаде бубрегот за „ајфон“, денес е неподвижен

Koга имал 17 години, денес 25-годишниот Ксао Ванг одлучил да го продаде својот бубрег за да купи телефон „ајфон 4“ и „ајпад 2“, бидејќи не можел да си ги овозможи. По операцијата, лекарите му рекле дека ќе води нормален живот со само еден бубрег, но осум години подоцна тој е неподвижен и секој ден оди на дијализа.
Пред осум години, „ајфон 4“ бил статусен симбол во средното училиште на Ксао. Со оглед на тоа дека потекнува од сиромашно семејство кое не можело да му го купи телефонот, одлучил да го продаде својот бубрег.
Ванг стапил во контакт со луѓето кои се специјализирани за продажба на органи на црниот пазар. Тие договориле цена од 22.000 јени или 2.800 евра, што му биле повеќе од доволно за посакуваните телефон и таблет од „Епл“. Посредниците за услугата добиле 8.700 евра и дополнителни 10.000 долари за самиот орган.
Лекарот кој го запознал пред операција му потврдил дека сè ќе биде во ред. Процедурата била изведена во илегална болница, а иако тогаш се сметала за успешна, набрзо се појавиле компликации. Ординацијата не била дезинфицирана, што довело до инфекции на раната.
Семејството на Ванг не знаело за неговата операција и дознале дури тогаш кога веќе не можел да ги сокрива здравствените проблеми.
Бидејќи не се осудувал да им каже што направил, инфекцијата се проширила и на неговиот здрав бубрег, а до моментот кога семејството го одвела во болница штетата веќе била толку сериозна што единствениот начин за да остане жив е трајна дијализа.
Ксао Ванг оттогаш поголемиот дел од животот го поминал во болница и сосема зависи од апаратите кои го одржуваат во живот, но истовремено и значително го намалуваат неговиот животен век.
Полицијата ги пронајде посредниците и лекарите, на кои судот им доделил по три години затвор. По покренатата тужба, родителите на Ксао добиле компензација од околу 300.000 eвра, но поголемиот дел од парите ги потрошиле за лекови и третмани.
Ново на Сител
-

Храната во светот поевтинува, кај нас - можно поскапување
-

АРМ: Шугата во велешката касарна доаѓа однадвор
-

Државните вили по 30 години добиваат имотен лист - СОЗР делумно се согласува во извештајот на Ревизија
-

Дали Охрид ќе остане на листата светско наследство на УНЕСКО - владина делегација на средби во Париз
-

Преглед на вестите од светот
-

Со „Безбеден град“ ќе се намалат прекршоците
-

209 милиони денари за изградба на дом за стари лица во Кочани
-

Преглед на вестите од светот